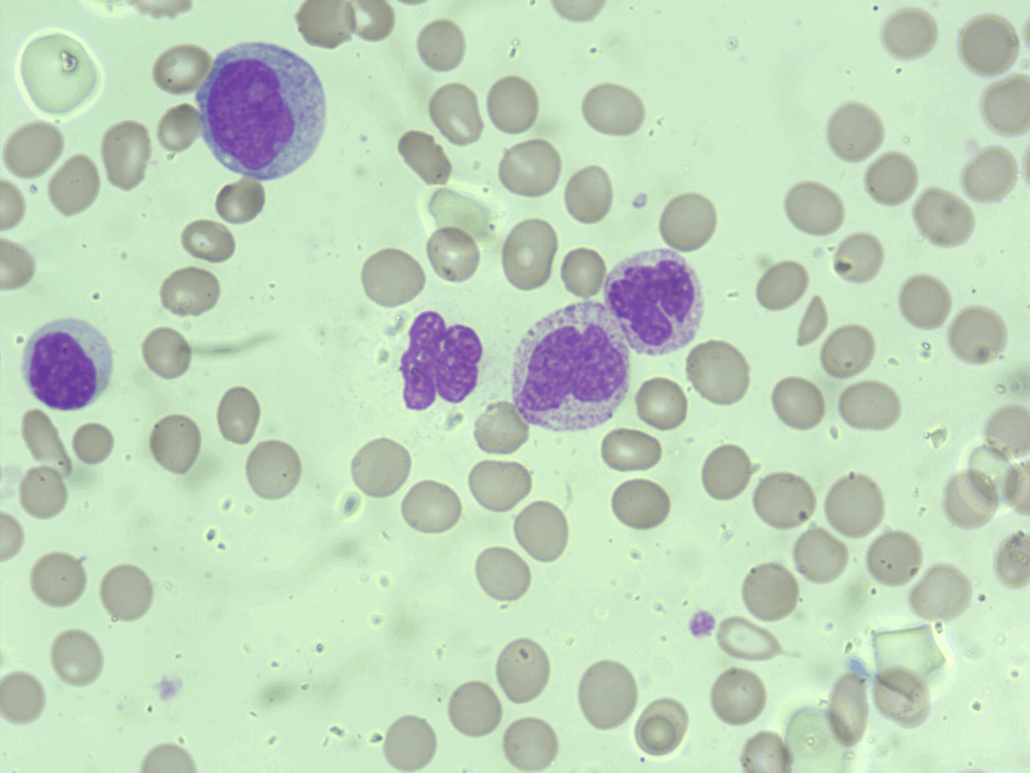
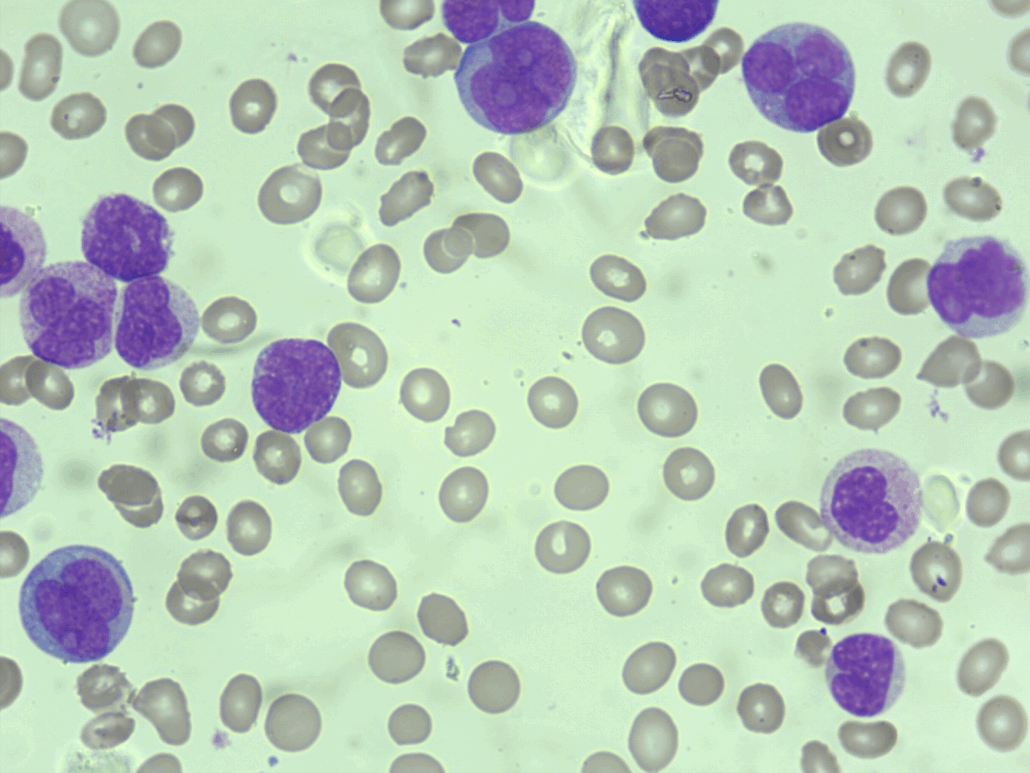

A crise blástica é a fase da LMC que é definida pela transformação da doença em um quadro semelhante a uma leucemia aguda, geralmente associada a um prognóstico desfavorável. Nessa etapa, ocorre perda de controle da proliferação clonal e diferenciação celular, o que resulta em acúmulo de blastos imaturos na medula óssea e no sangue periférico.
Esfregaço de paciente em crise blástica
Critérios diagnósticos para crise blástica
Segundo a OMS e outras classificações, a crise blástica é caracterizada por:
- Pelo menos 20% de blastos no sangue periférico ou na medula óssea
- Presença de blastos extramedulares (cloroma, infiltração tecidual)
Achados no hemograma da crise blástica
Leucocitose acentuada ou leucopenia
O hemograma pode mostrar leucócitos muito elevados ou, em contrapartida, nos casos mais avançados e refratários, queda do número total de leucócitos.
Blastos circulantes
Há presença marcante de blastos no sangue periférico, muitas vezes em grande proporção (≥20%).
Anemia
Observa-se queda importante da hemoglobina, geralmente normocítica e normocrômica, devido ao fato de que a medula óssea tem maior produção de blastos que das demais séries.
Trombocitopenia ou trombocitose
O mais comum é a trombocitopenia, refletindo falência medular. Todavia, em alguns casos iniciais, ainda pode haver trombocitose residual.
Hiato leucêmico
Diferente da fase crônica, onde há a “marcha leucocitária completa”, na crise blástica o predomínio é de formas imaturas (blastos e pró-mielócitos), enquanto há desaparecimento da maturação intermediária.
Basofilia e eosinofilia
Esses achados podem estar presentes, embora, na maioria das vezes, se tornem menos evidentes na fase blástica em comparação à fase crônica.
Esfregaço de paciente com crise blástica
Importância clínica e diagnóstica
O hemograma, associado ao mielograma e à imunofenotipagem, é fundamental para confirmar a progressão da LMC. Dessa forma, a transformação blástica indica necessidade de mudança imediata na conduta terapêutica, frequentemente com quimioterapia intensiva e avaliação para transplante de células-tronco hematopoéticas. Do ponto de vista prognóstico, trata-se de um marcador ruim, com sobrevida média dos pacientes significativamente reduzida.

Referências:
- Swerdlow SH, Campo E, Harris NL, et al. WHO Classification of Tumours of Haematopoietic and Lymphoid Tissues. IARC: Lyon; 2017.
- Hoffbrand AV, Higgs DR, Keeling DM, Mehta AB. Hoffbrand’s Essential Haematology. 8th ed. Wiley-Blackwell; 2019.
- Vardiman JW, Melo JV, Baccarani M, Radich JP. Chronic myelogenous leukemia, BCR-ABL1 positive. Blood. 2009;114(5):937-951.

